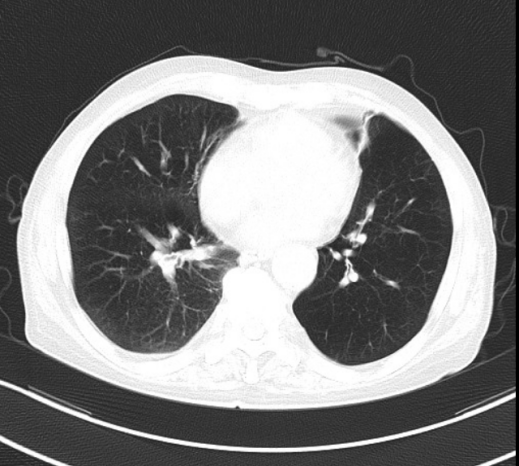

生命接力
近日,一场惊心动魄的“生命接力赛”在南方医科大学顺德医院附属杏坛医院上演。重症医学科(ICU)与呼吸内科通力协作,成功救治一名慢性阻塞性肺疾病急性加重、合并呼吸衰竭与感染性休克的危重患者。

患者为老年男性,到院时已陷入昏迷,呼吸微弱,血压测不出,血氧持续下降,生命危在旦夕。急诊紧急处置后,患者被直接转入ICU。ICU团队立即启动抢救流程:气管插管、呼吸机辅助通气、深静脉通道建立、血管活性药物精准泵入……经过数小时全力抢救,患者生命体征终于趋于平稳。

治疗前
治疗后
度过急性危险期后,治疗进入关键阶段——转呼吸内科进行后续专科康复。呼吸内科团队接过“接力棒”,制定个性化方案:无创呼吸机辅助、气道管理、肺康复训练、精准抗感染治疗。在医护人员的精心照护下,患者肺功能逐步改善,最终成功脱离呼吸机。

从ICU的生死竞速,到呼吸内科的精细康复,科室无缝衔接,展现了南方医科大学顺德医院附属杏坛医院多学科协作的综合救治实力。这也证明:危急重症的救治,不一定非要去大城市。在家门口的医院,同样有一支敢打硬仗的团队,有能力守住生命的最后防线。

患者已顺利出院。家属激动地送上锦旗:“是你们一次次不放弃,才把我父亲从鬼门关拉了回来!”每一面锦旗背后,都是一个家庭的希望。未来,南方医科大学顺德医院附属杏坛医院将继续提升急危重症救治能力,让更多患者在家门口得到及时、安心的救治。

编辑:水兴杏坛微信编辑小组
素材来源:南方医科大学顺德医院附属杏坛医院